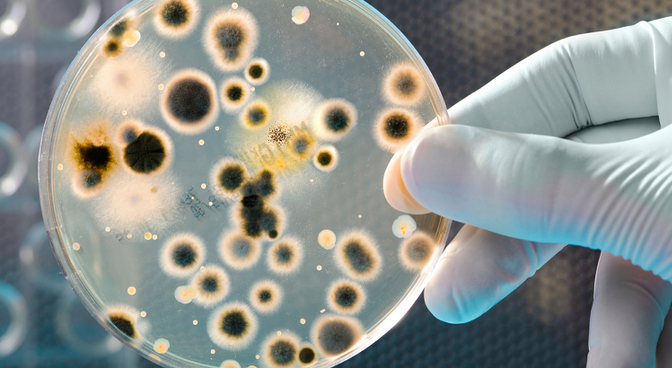
保证实验记录和数据完整性的要求 保证实验记录和数据完整性的要求

保证实验记录和数据完整性的要求
发布时间:2014-12-05 浏览次数:1677次
实验室分析结果的可靠性和可信性是一个基本的期望和要求,以反映实验室的实际工作。自从2005年的Able实验室丑闻发生以来,制药行业质量控制实验室的数据完整性一直都是监管机构核查的重点。尽管这样,从FDA发布的警告信来看,不可靠的或不可信的,甚至欺诈性实验数据的发生率仍然居高不下。
实验记录要想变得可靠和信赖,必须符合以下条件:
• 易读性
• 可归属性
• 实时性
• 原始性
• 准确性
• 完整性
• 连贯性
• 不可删除性
• 可用性
易读性
除了记载宝藏的四十二章经和用来记载武功的圣火令上的蝌蚪文,实验记录不得采用人类失传或只有世外高人才能懂的语言书写。不能被读出或理解的记录没有价值并且可能被当废纸扔掉。所有实验记录应当遵循一致的语法规则。坚决避免采用俚语、暗号、吐火文等不易于理解的语言记录。这也是实验记录要引入第二个人进行见证的原因,见证人在这里要行使监督权。
可归属性
任何一份实验记录的创建都要能归属到具体的作者,对于纸质记录而言由个人签署并注明签署日期。你得明白你签署的是一份具有法律效力的文件,也许这份文件在法庭上作为呈堂证供,你应该清楚地你的签名和含义
实时性
所有记录必须在具体活动发生的时间进行撰写。延迟撰写将不可避免地影响到记录的准确性,有人会遗忘一些细节,而有人会产生错误的记忆。
原始性
所有记录必须是第一手的记录,而不能是二次记录。该规定的目的主要是避免在誊抄时引入错误。
准确性
实验室记录必须反映实际发生的事情。任何更改都不应该擦除原始信息,采用修正液进行涂改是绝不允许的。对记录进行修改必须有修改人员的签名和修改日期,及修改理由。
完整性
数据的完整性对于不同的实验类型来说具有不一样的内涵。数据的来源和数据的类型都会对完整性的保持提出不一样的挑战。通常,我们最易于在分析实验室遭遇数据完整性问题,对于一个样品分析来说,除了样品本身的分析结果,还需要系统适用性测试报告、进样序列、数据处理方法、样品制备过程等。如果样品存在重复金阳或重复分析,这些数据也要保留,否则将大大降低样品分析结果的可信度。
永远记住“没有记录就等于没有发生”。
具有逻辑连贯性
这里的逻辑连贯性是指实验室发生的一些列活动应该具有时间上的逻辑性,包括时间上的顺序,空间上顺序。具体到一个样品分析实验来说,必须有合乎逻辑的先后发生顺序。例如,HPLC的运行在时间上不可能发生在样品准备后之前,样品的称量时间与色谱的进样时间应该有几个小时的时间差,以备充足的时间准备样品。因此,所有的日期/时间签署应该符合逻辑,这也是现场核查时专家经常检查的地方。
为了避免在这方面的混乱,特别是国内非常多地使用单机版的色谱仪器,需要确保所有产生的日期/时间标记打印输出的仪器都能实现时间同步器,由授时服务器统一授时,或与国家在线时间服务器同步。
不可删除性
不可删除性有两方面的意思,一是在记录的生命周期内都要保持清晰可读,二是一旦创建就不能删除。手写记录输入应该用水笔书写,而不是铅笔。
如果记录是在热敏纸上打印出来的,随着时间的推移记录会变暗,这时就需要及时地影印,并能确保与原件一致,将影印件附在原件后面。
我们在实验室经常看到实验记录本里会粘贴很多打印件,那么在粘贴打印件时也要注意以下两点:
使用无酸胶水或工业级的透明胶带
签名和日期时应该采用骑缝的方式,即字迹跨越粘贴件和记录本页面。
可用性
所有记录应随时可供检查,审计。如果监管机构要求审核某个文件,我们应做到三十分钟内就能呈递。因此,实验室应当建立便于引用归档系统。记录应封存并以保持其完整性,如,限制访问的安全设施、有效的防火措施、防止受潮等等。
上一条:SAP与LIMS之间的集成简述
